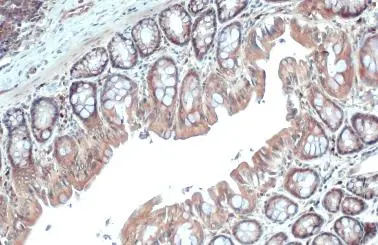
Adenosine Deaminase antibody detects Adenosine Deaminase protein at cytoplasm by immunohistochemical analysis. Sample: Paraffin-embedded rat colon. Adenosine Deaminase stained by Adenosine Deaminase antibody (GTX101390) diluted at 1:500. Antigen Retrieval: Citrate buffer, pH 6.0, 15 min

Various whole cell extracts (30 μg) were separated by 10% SDS-PAGE, and the membrane was blotted with Adenosine Deaminase antibody (GTX101390) diluted at 1:1000. The HRP-conjugated anti-rabbit IgG antibody (GTX213110-01) was used to detect the primary antibody.
Adenosine Deaminase antibody
GTX101390
ApplicationsWestern Blot, ImmunoHistoChemistry, ImmunoHistoChemistry Paraffin
Product group Antibodies
ReactivityHuman, Mouse, Rat
TargetADA
Overview
- SupplierGeneTex
- Product NameAdenosine Deaminase antibody
- Delivery Days Customer9
- Application Supplier NoteWB: 1:500-1:3000. *Optimal dilutions/concentrations should be determined by the researcher.Not tested in other applications.
- ApplicationsWestern Blot, ImmunoHistoChemistry, ImmunoHistoChemistry Paraffin
- CertificationResearch Use Only
- ClonalityPolyclonal
- Concentration1 mg/ml
- ConjugateUnconjugated
- Gene ID100
- Target nameADA
- Target descriptionadenosine deaminase
- Target synonymsADA1, adenosine deaminase, adenosine aminohydrolase
- HostRabbit
- IsotypeIgG
- Protein IDP00813
- Protein NameAdenosine deaminase
- Scientific DescriptionThis gene encodes an enzyme that catalyzes the hydrolysis of adenosine to inosine. Various mutations have been described for this gene and have been linked to human diseases. Deficiency in this enzyme causes a form of severe combined immunodeficiency disease (SCID), in which there is dysfunction of both B and T lymphocytes with impaired cellular immunity and decreased production of immunoglobulins, whereas elevated levels of this enzyme have been associated with congenital hemolytic anemia. [provided by RefSeq]
- ReactivityHuman, Mouse, Rat
- Storage Instruction-20°C or -80°C,2°C to 8°C
- UNSPSC41116161